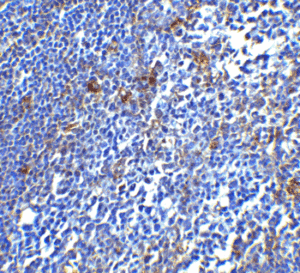
ProSci PD-1 Antibody (ProSci Cat #: 4065, Genesee Cat #: GS1-681) Immunohistochemistry Validation of PD-1in Human Tonsil Tissue

There has been significant interest in the role of programmed cell death protein 1 (PD-1) and its ligand programmed death-ligand 1 (PD-L1) in modulating immune responses. The emergence of PD-1-targeted therapies has revolutionized cancer treatment, leading to a better understanding of immune checkpoint mechanisms and their uses in various research fields.
This paper offers a review of significant publications on the use of PD-1 antibodies in cancer, immunology, and Alzheimer’s disease research. We will highlight the importance of PD-1 antibodies in resolving the complicated interactions between the immune system and pathological conditions as well as their potential to create novel therapeutic approaches.

The ProSci PD-1 antibody has been used in a variety of cancer, immunology, and Alzheimer’s disease investigations. Researchers have successfully detected PD-1 expression in a several of study settings with the highly specific rabbit polyclonal anti-PD-1 antibody (ProSci Cat #: 4065).
The ProSci PD-1 antibody has been found to be effective in improving our understanding of the immune system’s participation in many pathological conditions, and it has aided in the development of novel therapeutic strategies.
Learn More: https://www.prosciantibodies.com/product/pd-1-antibody-4065/

Figure 1: ProSci PD-1 Antibody (ProSci Cat #: 4065) Western Blot Validation in Human and Mouse Cell Lines
Loading: 15μg of lysates per lane. Antibodies: PD-1 (ProSci Cat #: 4065) (4μg/mL), 1h incubation at RT in 5% NFDM/TBST
Secondary: Goat anti-rabbit IgG HRP conjugate at 1:10000 dilution
Figure 2: ProSci PD-1 Antibody (ProSci Cat #: 4065) Immunohistochemistry Validation of PD-1in Human Tonsil Tissue Tissue was fixed with formaldehyde and blocked with 10% serum for 1h at RT; antigen retrieval was by heat mediation with a citrate buffer (pH6). Samples were incubated with primary antibody overnight at 4°C. A goat anti-rabbit IgG H&L (HRP) at 1:250 was used as a secondary antibody and was counter-stained with Hematoxylin.
In the study “Elucidating the Efficacy of the Bacille Calmette-Guerin Vaccination in Conjunction with
First Line Antibiotics and Liposomal Glutathione” 1, researchers investigated the combined effects of
BCG (Bacille Calmette-Guerin) vaccination and ex-vivo glutathione (GSH) enhancement on improving
immune responses against Mycobacterium tuberculosis (M. tb) infection.
They examined immune response effectiveness, CD4+ and CD8+ T cells in granulomas, liposomal glutathione (L-GSH) response, antibiotic levels, PD-1 expression, and autophagy induction. The results demonstrated that BCG vaccination, along with GSH enhancement, prevented CD4+ and CD8+ T cell loss in granulomas, improved M. tb infection control, reduced PD-1 expression, and increased autophagy and cytokine production (IFN-γ and TNF-α).
The ProSci rabbit polyclonal anti-PD-1 antibody (ProSci Cat #: 4065) was used to measure PD-1 expression in FFPE tissue samples. The results revealed a decrease in PD-1 expression due to BCG vaccination in immune responses against M. tb infection.
In the study “Microglial PD-1 stimulation by astrocytic PD-L1 suppresses neuroinflammation and
Alzheimer’s disease pathology” 2, researchers investigated the role of the PD-1/PD-L1 immune
checkpoint in Alzheimer’s disease (AD). They demonstrated upregulated expression of PD-L1 in
astrocytes and PD-1 in microglia surrounding amyloid plaques in AD patients and the APP/PS1 mouse
model.
Deletion of microglial PD-1 resulted in increased amyloid-beta (Aβ) deposition, reduced microglial Aβ uptake, and decreased expression of the Aβ receptor CD36 on microglia. These findings suggest that ineffective immune regulation by the PD-1/PD-L1 axis contributes to Aβ plaque deposition during chronic neuroinflammation in AD.
The ProSci rabbit polyclonal anti-PD-1 (ProSci Cat #: 4065) and anti-PD-L1
(ProSci Cat #: 4059) antibodies were used to measure the expression levels of
PD-1 and PD-L1 in FFPE tissue samples from Alzheimer’s patients.
In the study “Diffuse variant of lymphocyte-predominant Hodgkin lymphoma: a diagnostic challenge” 3, researchers presented a rare case of diffuse variant nodular lymphocyte-predominant Hodgkin lymphoma (D-LPHL) in a 35-year-old Caucasian female with left cervical and right axillary lymphadenopathy. Histopathological examination revealed large atypical lymphoid cells with a characteristic phenotype. Immunohistochemical studies confirmed the diffuse nature of the lymphoid proliferation, and the associated T cell microenvironment showed increased CD57(+) T cells. The report discusses the diagnostic criteria and provides a review of the literature on the differential diagnosis of this rare condition.
The ProSci rabbit polyclonal anti-PD-1 (ProSci Cat #: 4065, Genesee Cat #: GS1-681) antibody was used to detect the expression of PD-1 in FFPE tissue sample from this rare case of diffuse variant nodular lymphocyte-predominant Hodgkin lymphoma. The study highlighted the presence of PD-1-positive T cells exhibiting rosette formation around LP-type HL cells.
This paper highlights the significance of the ProSci PD-1 antibody in cancer, immunology, and Alzheimer’s disease research, demonstrating its effectiveness in understanding the immune system’s
role in various pathological conditions. The paper showcases the antibody’s potential in developing
novel therapeutic approaches and resolving complex interactions between the immune system and
diseases by analyzing key publications.
For more information on PD-1 research tools and other high performance antibody tools, contact ProSci Antibodies at customercare-prosci@geneseesci.com or visit www.geneseesci.com.
Learn more about PD-1 Antibody: https://www.prosciantibodies.com/product/pd-1-antibody-4065/
Share this post:
| Cookie | Duration | Description |
|---|---|---|
| cookielawinfo-checbox-analytics | 11 months | This cookie is set by GDPR Cookie Consent plugin. The cookie is used to store the user consent for the cookies in the category "Analytics". |
| cookielawinfo-checbox-functional | 11 months | The cookie is set by GDPR cookie consent to record the user consent for the cookies in the category "Functional". |
| cookielawinfo-checbox-others | 11 months | This cookie is set by GDPR Cookie Consent plugin. The cookie is used to store the user consent for the cookies in the category "Other. |
| cookielawinfo-checkbox-necessary | 11 months | This cookie is set by GDPR Cookie Consent plugin. The cookies is used to store the user consent for the cookies in the category "Necessary". |
| cookielawinfo-checkbox-performance | 11 months | This cookie is set by GDPR Cookie Consent plugin. The cookie is used to store the user consent for the cookies in the category "Performance". |
| viewed_cookie_policy | 11 months | The cookie is set by the GDPR Cookie Consent plugin and is used to store whether or not user has consented to the use of cookies. It does not store any personal data. |